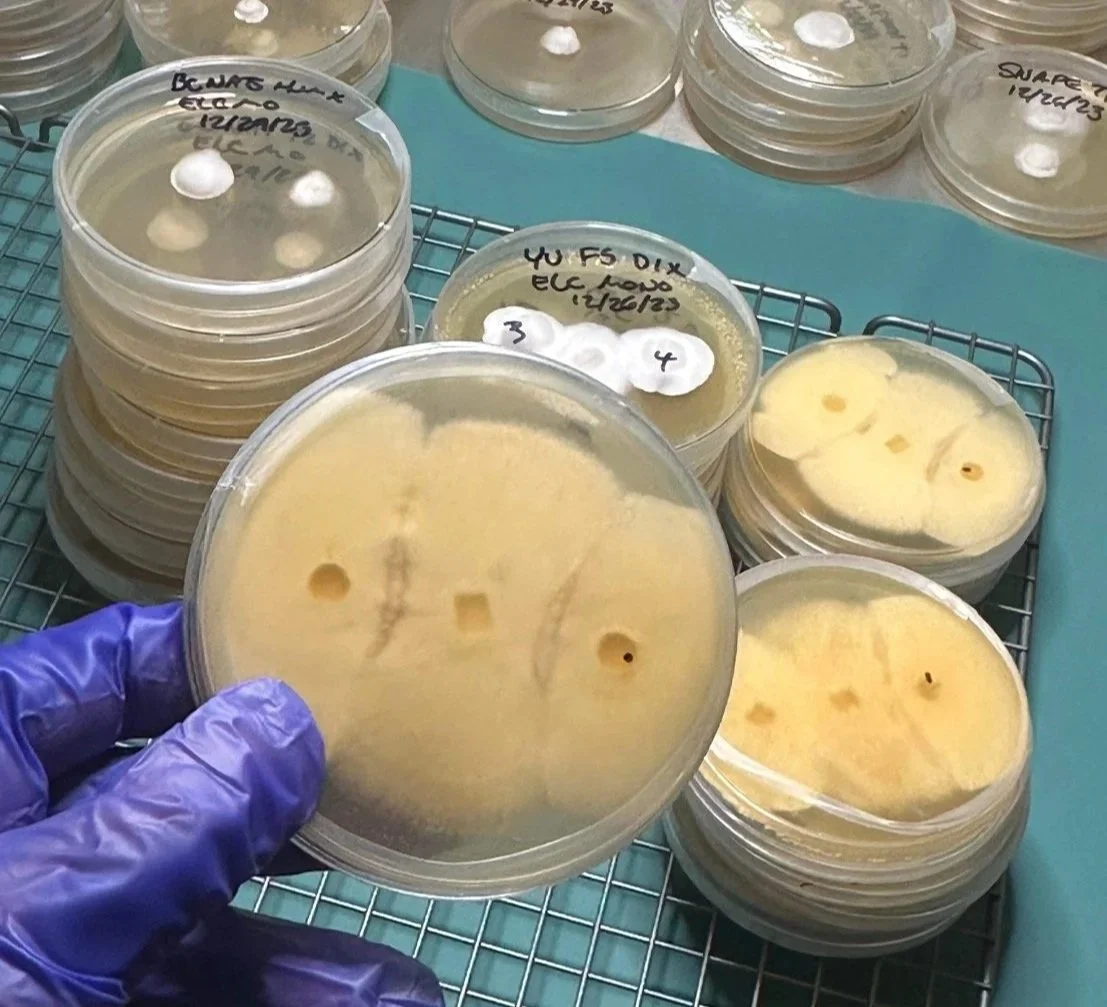
IMG_7303.jpg
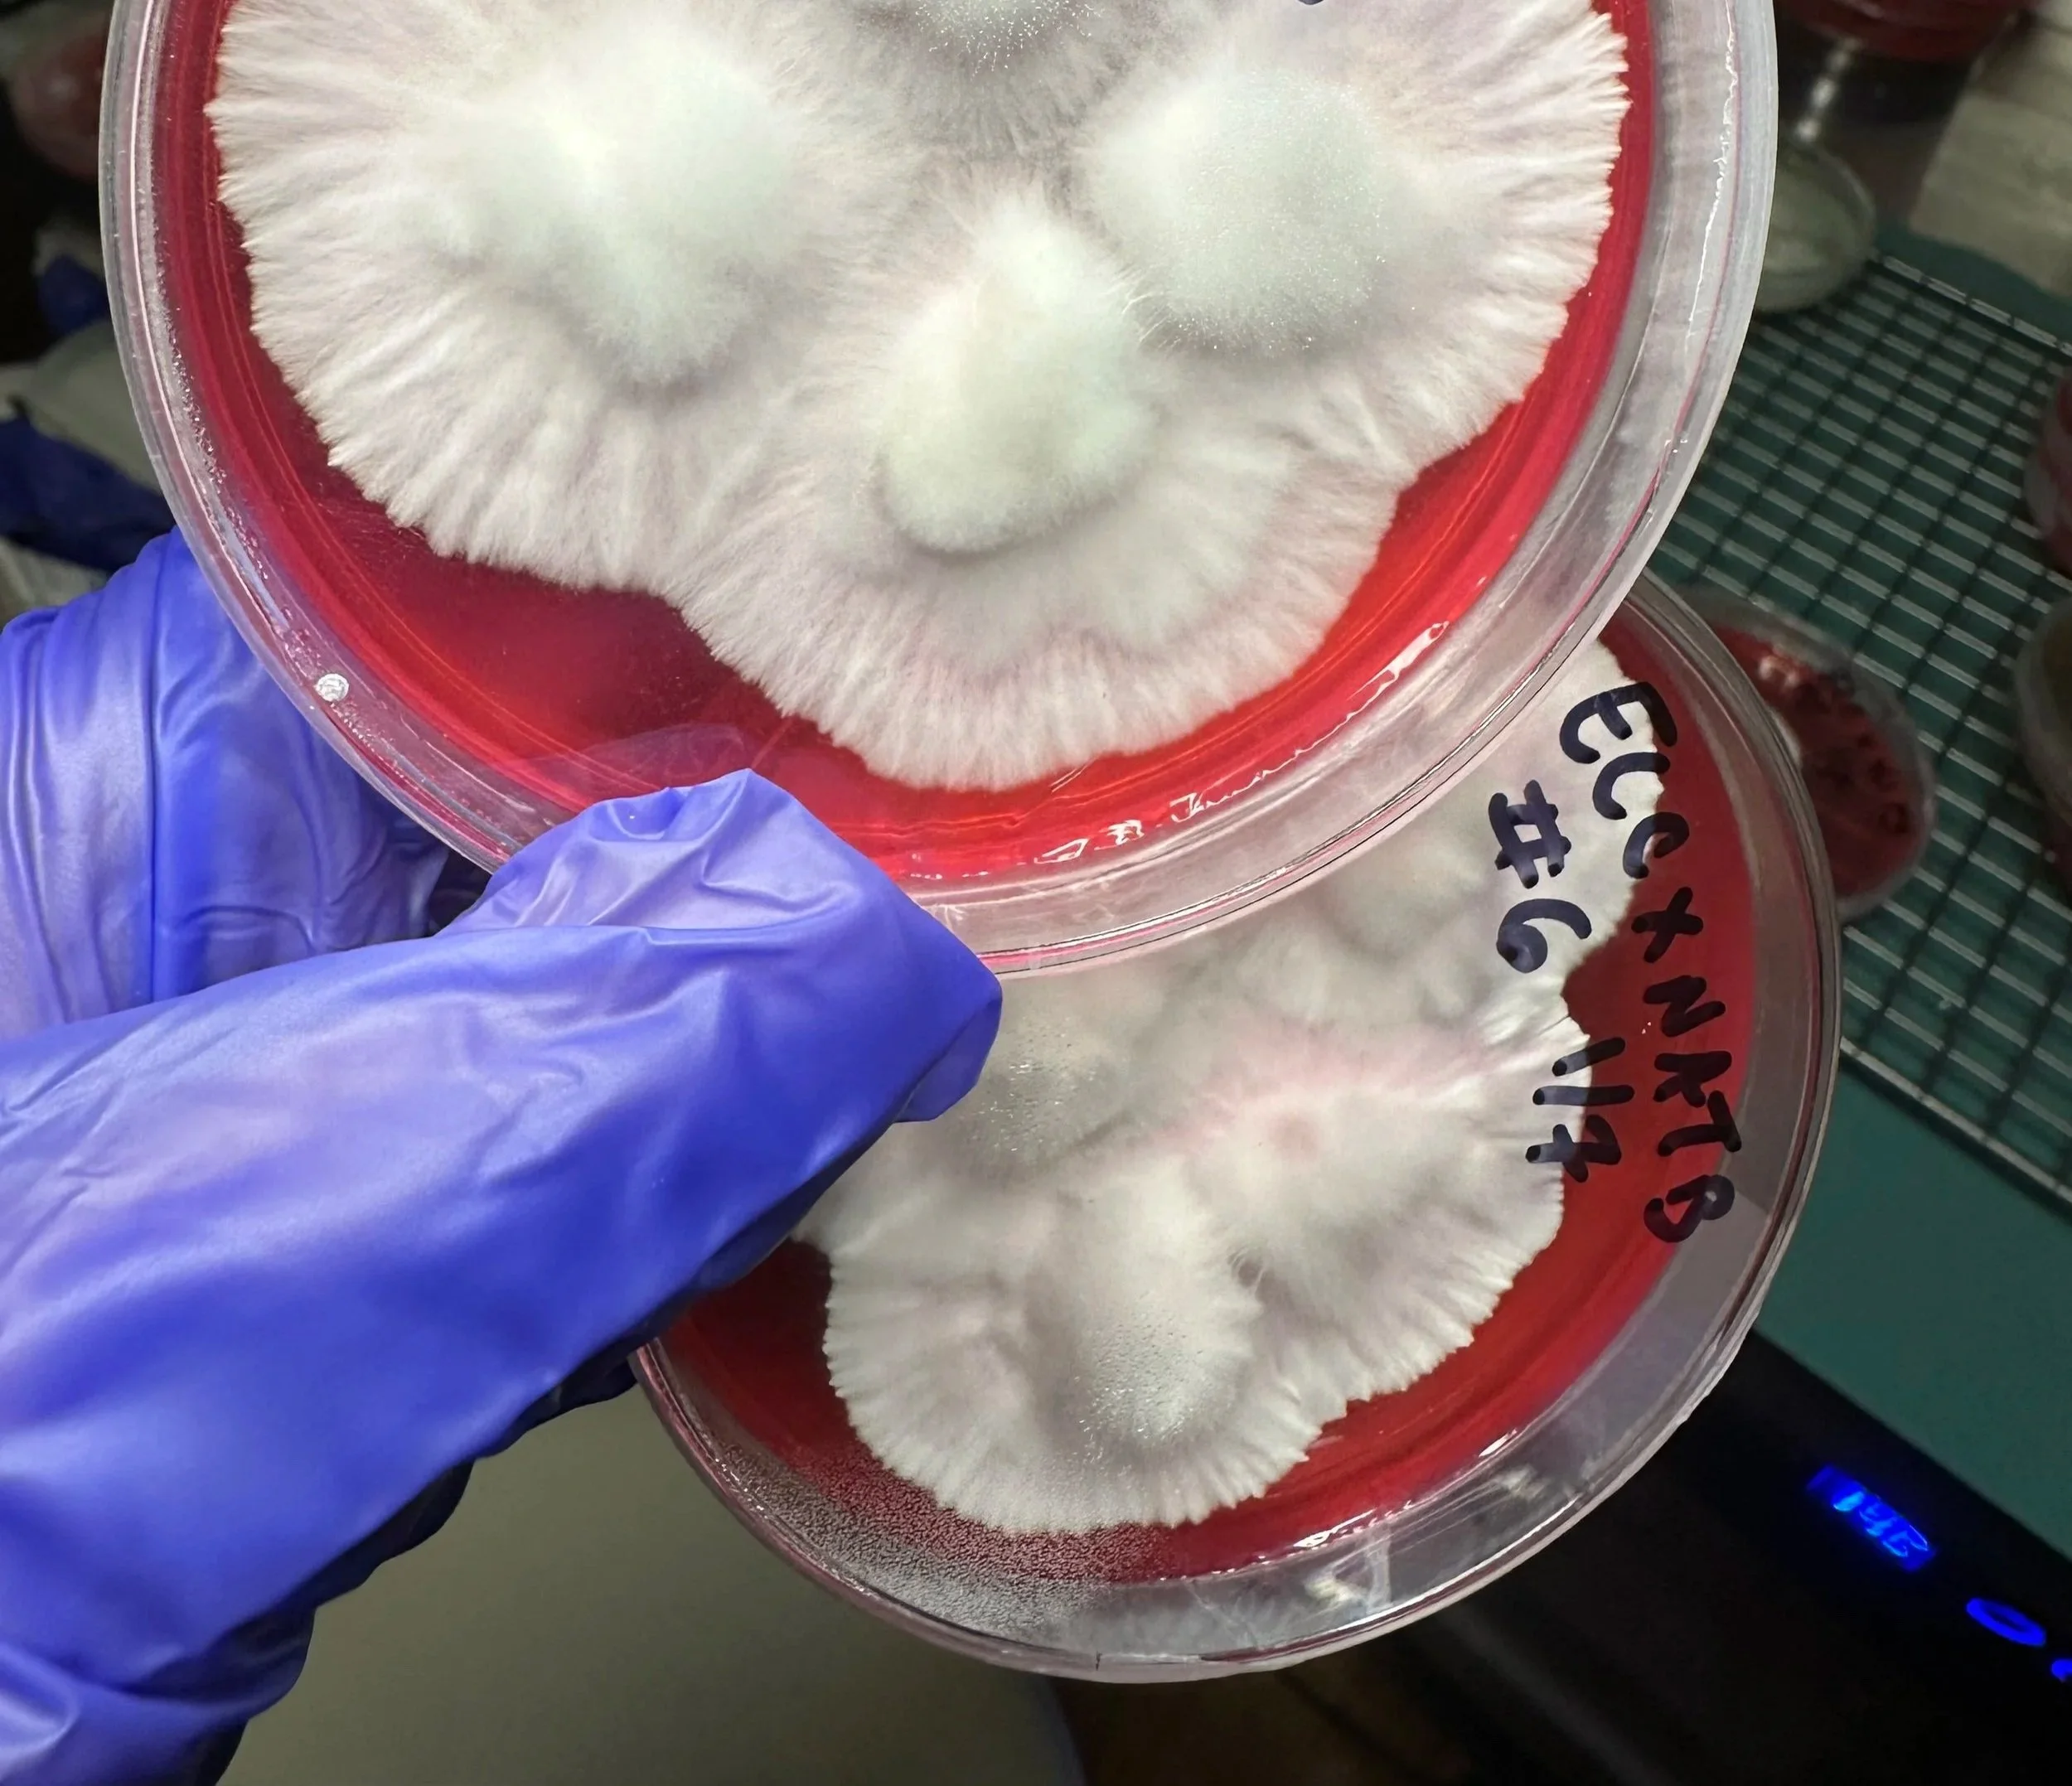
IMG_5082.jpg

Matka Breeding Project
Most efforts in Psilocybe genetics focus on increasing potency or creating visually distinct varieties. However, these goals do not always align with the needs of individuals seeking spiritual support for personal suffering, trauma, or other challenges that may manifest physically. From this perspective, the body can reflect deeper spiritual states, and the work of the Matka project is conducted within that context. My work has explored a newly described species, Psilocybe ochracentrata (previously misidentified as Ps. natalensis), which has been observed in spiritual practice to support individuals navigating manifestations of spiritual dis-ease, including conditions often described as anxiety or nerve-related tension, while offering a gentler experiential profile. Early observations of the Matka #7 cross in these contexts produced results that exceeded initial expectations, further motivating continued exploration.
Using the Buller phenomenon, a biological process in Basidiomycete fungi that enables compatible dikaryotic and monokaryotic mycelia to exchange nuclei, I created Di-Mon interspecies crosses between Ps. cubensis “El Choco” (B+ lineage) and Ps. ochracentrata “Natural Beauty.” This approach allows exploration of traits such as vigor and yield alongside the gentle, effervescent qualities observed in spiritual practice with reduced risk of nausea. Of approximately two dozen attempts, a subset produced stable crosses, with Matka #7 demonstrating accelerated growth and high yield under the conditions tested. Once Matka #7 and any other successful isolates are stabilized, they will be made available as gifts to academic institutions conducting research in this field.
This work is conducted as an expression of sincerely held religious belief and is intended to align with protections afforded under the Religious Freedom Restoration Act (RFRA). It is not intended to diagnose, treat, or make claims regarding medical or health conditions.